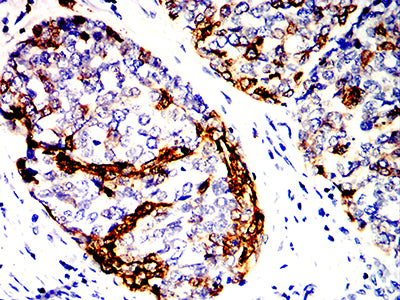

Mouse Monoclonal Antibody to KRT14
货号:
32350
别名:
K14; NFJ; CK14; EBS1; EBS3; EBS4; EBS1A; EBS1B; EBS1C; EBS1D
应用:
WB,IHC,IF,FCM
反应种属:
Human
抗体类型:
Primary antibody
Swissprot:
P02533
规格:
目录价
在线咨询
Description |
|---|
This gene encodes a member of the keratin family, the most diverse group of intermediate filaments. This gene product, a type I keratin, is usually found as a heterotetramer with two keratin 5 molecules, a type II keratin. Together they form the cytoskeleton of epithelial cells. Mutations in the genes for these keratins are associated with epidermolysis bullosa simplex. At least one pseudogene has been identified at 17p12-p11. |
References |
|---|
| 1.Br J Dermatol. 2020 Oct;183(4):756-757. 2.Sci Transl Med. 2021 Mar 24;13(586):eabb2914. |
Specification |
|
|---|---|
| Aliases | K14; NFJ; CK14; EBS1; EBS3; EBS4; EBS1A; EBS1B; EBS1C; EBS1D |
| Entrez GeneID | 3861 |
| Swissprot | P02533 |
| clone | 3A1F6 |
| WB Predicted band size | 51.5kDa |
| Host/Isotype | Mouse IgG1 |
| Antibody Type | Primary antibody |
| Storage | Store at 4°C short term. Aliquot and store at -20°C long term. Avoid freeze/thaw cycles. |
| Species Reactivity | Human |
| Immunogen | Purified recombinant fragment of human KRT14(AA: 115-472) expressed in E. Coli. |
| Formulation | Purified antibody in PBS with 0.05% sodium azide |
Application |
|
|---|---|
| WB | 1/500 - 1/2000 |
| IHC | 1/200 - 1/1000 |
| IF | 1/50 - 1/200 |
| FCM | 1/200 - 1/400 |
| ELISA | 1/10000 |
Product Image
-
Black line: Control Antigen (100 ng);Purple line: Antigen (10ng); Blue line: Antigen (50 ng); Red line:Antigen (100 ng)

-
Western blot analysis using KRT14 mouse mAb against A431 (1)cell lysate.

-
Immunofluorescence analysis of *** cells using *** mouse mAb (green). Blue: DRAQ5 fluorescent DNA dye. Red: Actin filaments have been labeled with Alexa Fluor- 555 phalloidin. Secondary antibody from Fisher (Cat#: 35503)

-
Flow cytometric analysis of Hela cells using KRT14 mouse mAb (green) and negative control (red).

-
Immunohistochemical analysis of paraffin-embedded human esophagus tissues using KRT14 mouse mAb with DAB staining.

-
Immunohistochemical analysis of paraffin-embedded human esophageal cancer tissues using KRT14 mouse mAb with DAB staining.

鄂公网安备42018502007531号
鄂公网安备42018502007531号

